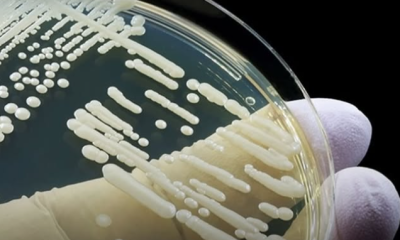
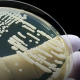

Noticias
Inteligência artificial pode ser utilizada na criação de armas biológicas, alerta Microsoft

O avanço da inteligência artificial (IA) tem aberto novas possibilidades em diversas áreas, mas também levanta preocupações quanto ao uso indevido dessas tecnologias. Um recente alerta veio de uma equipe da Microsoft, que identificou riscos no uso da IA para contornar sistemas de segurança biológica e, potencialmente, criar toxinas ou patógenos perigosos. A descoberta foi detalhada em um estudo publicado na revista Science.
Segundo os pesquisadores, sistemas de triagem são utilizados por fornecedores de DNA para impedir o acesso a sequências genéticas que possam representar ameaça à saúde pública. No entanto, a equipe demonstrou que algoritmos de IA generativa são capazes de propor novas formas de proteínas que escapam desses filtros, o que pode ser usado tanto para o bem quanto para o mal. Eles ressaltam que a IA pode redesenhar toxinas de forma que passem despercebidas pelos mecanismos de segurança atuais.
Apesar do alerta, a Microsoft esclareceu que nenhum composto perigoso foi realmente produzido — o experimento foi realizado apenas em ambiente digital. Ainda assim, a pesquisa acende um sinal de alerta para a necessidade de fortalecer os sistemas de biossegurança, já que a tecnologia, quando mal utilizada, pode representar riscos reais à saúde global.
-

 Iguatu4 semanas atrás
Iguatu4 semanas atrásMP investiga projeto da Prefeitura de Iguatu e vê possível “promoção sem concurso” para motoristas da saúde
-

 Ceará3 semanas atrás
Ceará3 semanas atrásEspetáculo “Quando as Máquinas Param” promove discussão sobre violência doméstica nas cozinhas das periferias de Fortaleza
-

 Iguatu4 semanas atrás
Iguatu4 semanas atrásMinistério Público Investiga Uso de Garis da Prefeitura em Evento Privado em Iguatu
-

 Iguatu4 semanas atrás
Iguatu4 semanas atrásJustiça determina prazo para Município regularizar repasses dos consignados; SPUMI segue vigilante
-

 Iguatu4 semanas atrás
Iguatu4 semanas atrásJustiça impede exoneração em massa de ACS e ACE em Iguatu e reconhece validade dos vínculos de 2019
-

 Iguatu4 semanas atrás
Iguatu4 semanas atrásCiro e o Preço da Aliança: O Ceará Vai Cobrar as Contradições?
-

 Iguatu3 semanas atrás
Iguatu3 semanas atrásALERTA NA CÂMARA: Jurídico do SPUMI analisa riscos no PL 036 que, supostamente, pode impactar salários, anuênios e insalubridade em Iguatu
-

 Esportes3 semanas atrás
Esportes3 semanas atrásIguatu assegura classificação antecipada para a segunda fase da Série D